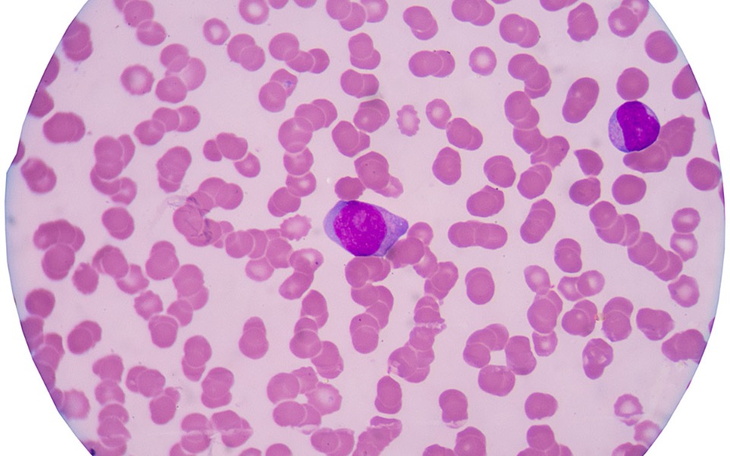
Zbiórka Pierwsza wizyta, transport. - zdjęcie główne

❤️!
Ciężko.
Robię to, bo czuję, że muszę. I choćby polał się hejt- trudno.
Nie wstawię zdjęć i nie wyobrażam sobie, bym mogła kogoś postawić w takiej sytuacji. Mam nadzieję, że to zrozumiecie.
Moja koleżanka nigdy nie prosiła nikogo o pomoc, choć wiele razy, a nawet setki razy pomagała innym, mi również. Nigdy nie odmówiła pomocy, a dziś sama stanęła pod ścianą i wiem, że będzie jej ciężko bez naszej pomocy…
U mojej koleżanki mamy podejrzewają białaczkę limfatyczną. Niestety badania, które muszą wykonać na NFZ, mają odległe terminy. Mama pracowała za granicą, aby pomóc córce w utrzymaniu jej rodziny, córce, która samotnie wychowuje swoje dzieci. Ona również pracuje, ale koszty wszystkiego, mieszkania i całej reszty są kolosalne, zresztą wiemy, jak teraz jest. Mama niestety znów źle się czuje i nie jest w stanie pracować. Musi wrócić do Polski. Nie mają wyjścia, trzeba zapisać się prywatnie. Wizyta u profesora, którego polecają to koszt 500 zł, plus paliwo na dojazd na wizytę, potem być może kolejna podróż do szpitala. Ona, jej mama i dzieci muszą w tym momencie utrzymać się z jednej pensji, polskich średnich zarobków. Jest ciężko.
A dziś usłyszałam przez tel: ,, Ja nawet nie mam na taką wizytę, a gdzie reszta, paliwo itd…”
Nie proszę o miliony, nie jest to dla mnie ani też nie dodam zdjęć tej rodziny, bo uważam, że to nie na miejscu. Kto mnie zna, wie, że nigdy nie wzięłabym nawet złotówki dla siebie przeznaczonej na inny cel…
To wszystko, co mogę zrobić..
Potrzebujemy na wizytę, paliwo… może to niedużo, dla niektórych jednak to jest teraz WSZYSTKO.
Oczywiście też się dorzucam❤️
Uważasz, że ta zbiórka zawiera niedozwolone treści ? Napisz do nas


Gdy świat się wali, dajemy nadzieję ❤️ Wspieramy chorych w pozyskaniu środków na leczenie, pomagamy zwierzętom i reagujemy natychmiast w pilnych sytuacjach kryzysowych 🚨
Jak odmienić los tysięcy potrzebujących za darmo?
✅ Wybierz Fundacja Pomagam.pl na liście OPP w rozliczeniu PIT.
✅ Wpisz nasz numer KRS 00 00 353 888 w deklaracji PIT.
Dla Ciebie to rubryka. Dla nich szansa, by przetrwać najgorsze.